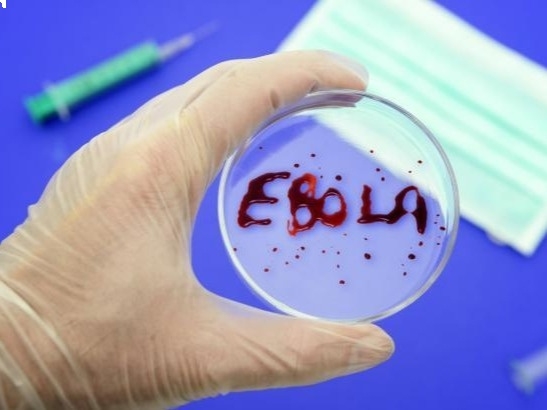

Ученые: вирус Эбола мутирует не так быстро, как изначально предполагалось
14:48, 27 Март, 2015
14:48, 27 Март, 2015Вирус Эбола в Западной Африке мутирует не так быстро, как изначально опасались специалисты. К такому выводу пришли специалисты из Национального института аллергических и инфекционных заболеваний США, изучающие развитие эпидемии на протяжении девяти месяцев после ее начала, сообщает Арменпресс со ссылкой на Тасс.
Согласно их новому отчету, опубликованному в четверг в журнале Science, темпы мутации смертоносного вируса оказались за этот период примерно такими же, как и при прежних вспышках заболевания. Более того, по оценкам американских ученых, в период с июня по ноябрь прошлого года генетический код вируса Эбола оставался относительно стабильным, несмотря на массовое распространение инфекции. "По нашим данным, вирус Эбола не претерпевает быстрой эволюции в организмах людей в ходе нынешней эпидемии", - констатируют авторы отчета.
Директор Национального института аллергических и инфекционных заболеваний Энтони Фаучи назвал отчет "хорошей новостью" для врачей, борющихся с распространением эпидемии. "Согласно новым данным, весьма маловероятно, что вирус будет мутировать и менять пути своего распространения", - заявил специалист.









